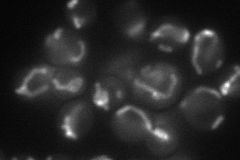
YBR179c
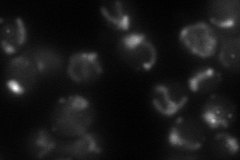
YBR179c
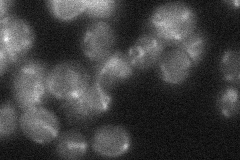
YBR179c
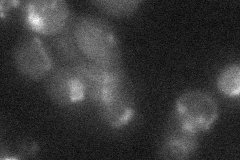
YBR179c

Fzo1
View description
Mitofusin, mitochondrial integral membrane protein involved in mitochondrial fusion and mitochondrial genome maintenance; contains N-terminal GTPase domain; targeted for destruction by cytosolic components of the ubiquitin-proteasome system
Localization:
Intensity:
Fold change:
Significance:
-
C’ GFP library in SD

mitochondria23.57 -
N' NOP1pr-GFP in SD
mitochondria55.3661 -
N' TEF2pr-mCherry in SD
mitochondria58.6992 -
N' NATIVEpr-GFP in SD
mitochondria22.7093 -
N' TEF2pr-VC and Cyto-VN in SD
punctate,mitochondria35.3098 -
C’ GFP library in SD+DTT

mitochondria22.120.93No -
C’ GFP library in SD+H2O2

mitochondria22.50.95No -
C’ GFP library in Starvation Media

mitochondria26.661.13No -
C’ GFP library on the background of Pup2-DaMP

mitochondria -
C’ GFP library on the background of CCT mutant

mitochondria17.65190.74862No
